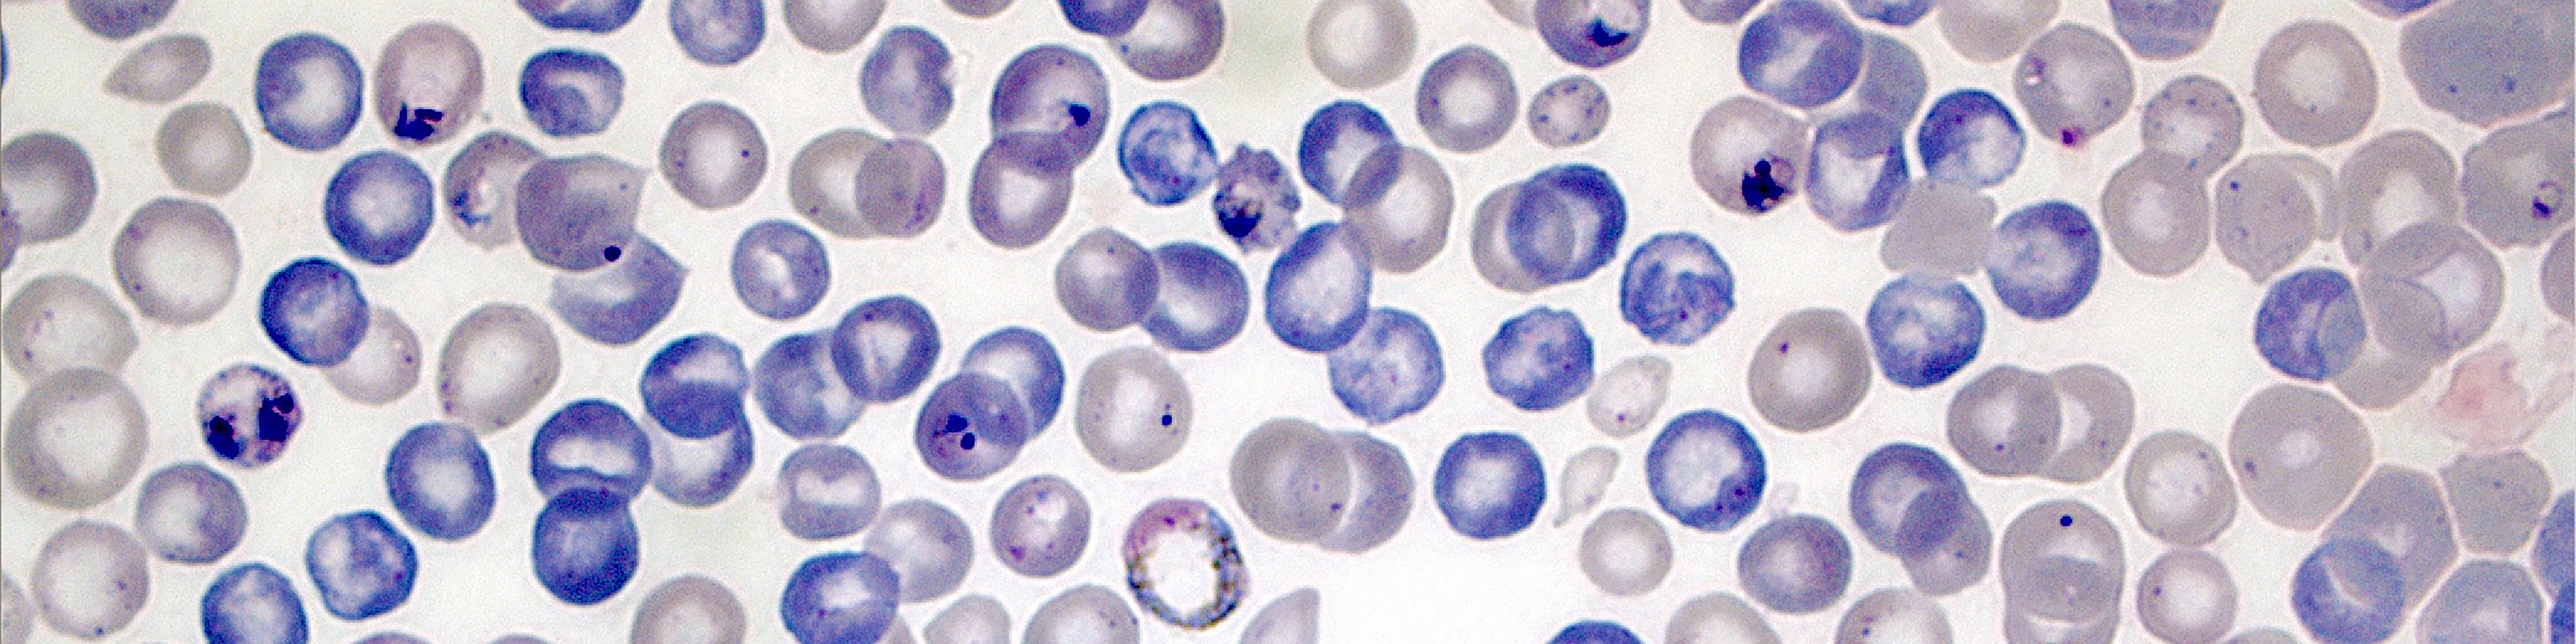
Microscopic image of malaria infected blood cells in purple and blue colours

How to order
If you wish to order reagents from the European Malaria Reagent Repository, please email: emrr@ed.ac.uk.
Please add the following details in your email:
- Specific reagent(s) you require
- Number of vials you require (approx. 100microg each) per reagent
- Full address
- Contact number
- contact email address
- VAT exemption number
If you are ordering from the UK and the EU please also provide
EORI Number
If you are ordering from the EU and overseas, please also provide
- Any essential document for shipping this kind of reagent to your country
We will prepare the Customs Invoice and the Description of Contents Letters on our side.
Monoclonal antibody (mAb) ordering:
If you are ordering from the UK or the EU
Please tell us your preference on how to ship the mAbs: on dry ice or at ambient temperature with azide added (which is cheaper, simpler and quicker than a dry ice shipment). Be aware that azide will kill live parasites, but if the mAbs are to be used for assays such as western blots or IFAs the presence of azide is not a problem.
If you are ordering from outside the EU
The antibodies will be shipped on dry ice or azide
Parasite lines ordering:
Will be shipped on dry ice
Cost
The repository was originally set up with funding from the Wellcome Trust, but now has no external source of funding and has to generate enough income from reagent provision to be sustainable.
Currently, for academic researchers, standard reagents cost £300 each, with discounts for multiple reagents.
Quantity | Price per tube | Discount |
1–4 | £300 | — |
5–9 | £285 | 5% |
10–19 | £270 | 10% |
20+ | £255 | 15% |
Prices for commercial and other non-academic research organisations, and for non-standard requests will be higher; please enquire.
Payment method:
We normally require a Purchase Order document including all the costings of the quote in GBP. If a Purchase Order cannot be provided alternative methods are available.
Once the Purchase order is provided an official invoice will be sent to the customer
Shipping
The costs of shipping, packaging and currency charges must also be paid by those ordering reagents. Most reagents need to shipped on dry ice, via couriers, and are therefore classified as dangerous goods, so shipping costs by air can be considerable.
Please email your requirements to us and we will send a quotation to you. If this is acceptable, we will invoice you before shipment.
Parcels containing dry ice are normally shippen on Tuesdays to allow them to arrive to their destination by the end of the same week.
As soon as the courier collects the parcel a Tracking number will be sent to the customer to locate where their parcel is in the shipping process.